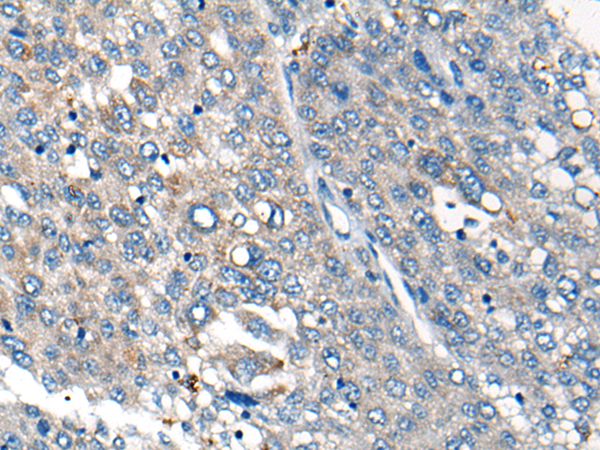
一抗

Background:
This gene encodes the third of three enzymes that posttranslationally modify isoprenylated C-terminal cysteine residues in certain proteins and target those proteins to the cell membrane. This enzyme localizes to the endoplasmic reticulum. Alternative splicing may result in other transcript variants, but the biological validity of those transcripts has not been determined.
Applications:
ELISA, IHC
Name of antibody:
ICMT
Immunogen:
Synthetic peptide of human ICMT
Full name:
isoprenylcysteine carboxyl methyltransferase
Synonyms:
PCMT; PPMT; PCCMT; HSTE14; MST098; MSTP098
SwissProt:
O60725
ELISA Recommended dilution:
5000-10000
IHC positive control:
Human liver cancer
IHC Recommend dilution:
25-100
技術規格


 購物車
購物車 幫助
幫助
 021-54845833/15800441009
021-54845833/15800441009